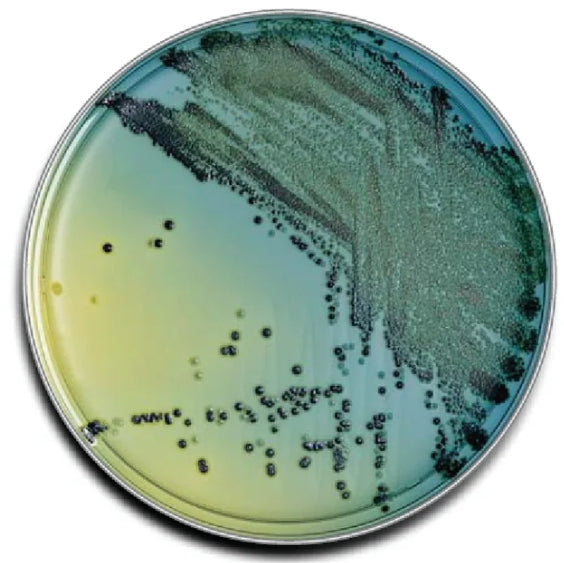
BD BBL™ MUELLER HINTON II AGAR PLATE, 150MM -221800, Pack

BD BBL™ MUELLER HINTON II AGAR PLATE, 150MM -221800, Pack
BD BBL™ MUELLER HINTON II AGAR PLATE, 150MM -221800, Pack . Ships directly from manufacturer.
Safety & Compliance Documents
Safety & Compliance Documents
Material Safety Data Sheets (MSDS) or Safety Data Sheets (SDS) are available upon request for applicable products. Please contact us if you need documentation for regulatory or compliance purposes.
Disclaimer
Disclaimer
Important Notice: Product images, descriptions, and titles are for reference only and may not always perfectly represent the actual item. Please look at the manufacturer item code to ensure it matches the product you need before purchasing.
For any medical supplies or devices that require a prescription, a valid prescription from a licensed healthcare provider is required before use. Some products may have special shipping conditions, such as refrigeration or weight-based restrictions. Additional shipping charges may apply which are not calculated automatically.
Certain products can only be shipped to facilities with specific licenses or regulatory approvals. Before processing your order, our team will request the necessary documentation. Orders will only be shipped once verification is successfully completed.
Product pricing and availability are subject to manufacturer updates and changes. SNT Biotech reserves the right to modify or cancel orders that do not align with business policies.
Additionally, certain drop-shipped items may be subject to additional taxes that are not automatically calculated at checkout.
For any questions or further assistance, please contact us via email or call (312) 715-7101.
Description
Description
Payment & Security
Payment methods
Your payment information is processed securely. We do not store credit card details nor have access to your credit card information.